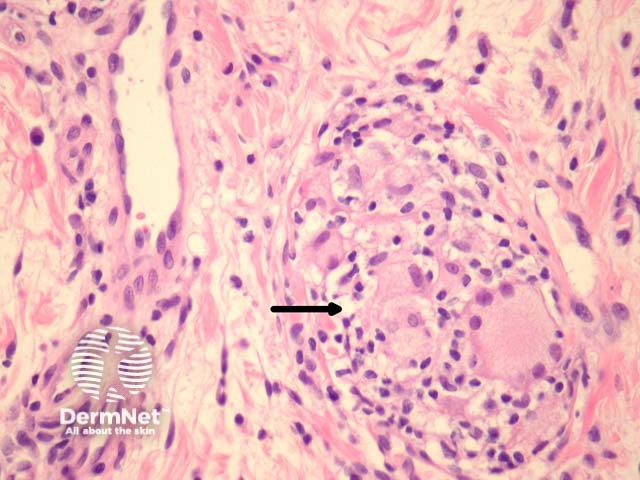
Figure 2

Main menu
Common skin conditions
NEWS
Join DermNet PRO
Read more
Quick links
Lesions (benign) Diagnosis and testing
Author: Assoc Prof Patrick Emanuel, Dermatopathologist, Auckland, New Zealand, 2013.
Orofacial granulomatosis is also referred to as granulomatous cheilitis, and is characterised clinically by chronic/relapsing swelling of the lips and oral mucosa.
In orofacial granulomatosis, sections show oral mucosa with a sparse inflammatory infiltrate and mild oedema (figure 1). Higher power examination shows ectasia of lymphatics next to rare loose granulomas (figures 2-4, arrows indicate granulomas). Sometimes the granulomas may be difficult to find and extensive serial sectioning of the biopsy is recommended.

Figure 1
Figure 2

Figure 3

Figure 4
Special stains for microorganisms may be performed to rule out an infection, given the granulomatous nature of the infiltrate.
Melkersson-Rosenthal syndrome: Shows the exact same pathology but clinically also shows facial nerve palsy and a “scrotal” tongue.
Crohn disease: Oral involvement with Crohn disease will be histologically identical. Clinical correlation is needed.
Sarcoid: Sarcoidal granulomas tend to be more overt and larger but some cases can be difficult/impossible to distinguish from orofacial granulomatosis.